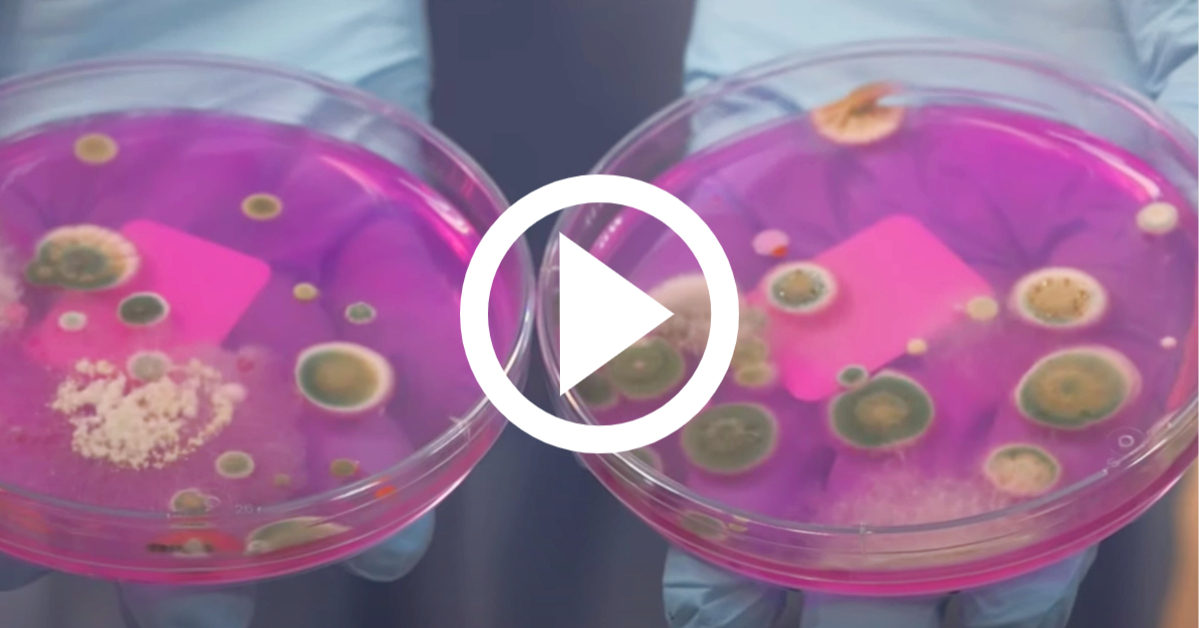

Media

News | March 25, 2025
Testing You Trust: Reliable Testing Services
As the largest family-owned, privately held third-party testing company in the nation, our locations across the country operate with a level of authenticity, integrity, urgency and excellence that few others can off
Read More
News | March 25, 2025
Food Manufacturers One-Stop Testing Shop
From farm to fork, we help you manage your food quality and safety risks to protect consumers and their brands.
Read More

News | March 25, 2025
Television News Crew Inside High-Security Testing Lab
Director and Leading Virologist Steve Zhou welcomed award-winning journalist Maya Rodriguez and her television news crew, to get a never-before-seen look into his high-security lab on the forefront of the fight against pandemics like COVID-19.
Read More

News | March 25, 2025
Food Manufacturers Nutrition Label Updates
From industry-leading regulatory experts like Nelson and Cogley to affordable pricing, unmatched labeling technology, and even rush options, Microbac is the best partner for any small and mid-sized food manufacturers looking for guidance and solutions in the race to re-label.
Read More

News | February 5, 2025
Unhappy with Your Pharmaceutical Testing Lab? We Can Help
To serve the unique needs of our clients in the bio/pharmaceutical, medical device, infection control, and personal care products, we provide full-service analytical testing and customized packages that deliver the data essential for critical decision-making every day.
Read More

News | January 25, 2025
Test Facility Surfaces to Reopen Your Business with Confidence
The health of your employees and customers is our number one priority. As an essential business, Microbac is one of the only labs in the country qualified to help you remain open, or reopen, with renewed confidence.
Read More

News | June 25, 2024
Test Your Drinking Water for Lead with Microbac Laboratories
We offer a full range of drinking water analyses and provide timely, reliable data to help you manage your compliance requirements.
Read More

News | April 25, 2023
Inside High Security Lab Television Coverage
We are one of the only testing laboratories in the world certified by the CDC to test the effectiveness of disinfectants against COVID-19 and viruses like it
Read More

News | March 25, 2023
Keep Your Campus Safe With Wastewater Testing
Decision-makers have turned to a new, much stinkier way to detect and prevent the virus – and scientists at the nation’s leading private testing laboratory are hopeful it will bring the results schools need to remain open, safely.
Read More

Contact Us
Have questions or need expert testing solutions? Reach out to Microbac today, and let our team provide you with reliable and accurate testing services tailored to your needs. We’re here to support your business with trusted expertise.